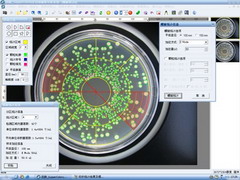

1、全方位的菌落统计功能
V3能根据颜色、菌落轮廓特征来识别特定的菌落;
自动剔除培养基中杂质的干扰;根据国家标准处理相互粘连的菌落。
2、数据库管理,保证实验数据的安全
V2设计的数据库系统不仅能保存菌落的图片和全部的统计数据,
还能根据名称、编号、日期等,轻松查询以往数据;并严格管理
使用者权限、参数设置和数据修改权限。
--------------------------------------------------------------------------

3、瞬间菌落计数,同时实现大肠菌群快速测定
V2采用“迅数”colonfast菌落智能识别技术,真彩动态CMOS和
高速图像传输接口,常规平皿统计只需1秒。同时利用颜色识别功能,
可进行大肠菌群快速测定,真正实现一机多用。
-----------------------------------------------------------------------------------------------------------------

4、300万像素高清晰真彩CMOS,透视深层细小菌落
全新设计的全封闭拍摄箱辅以全空间、宽光带和悬浮式暗视野装置,
彻底解决了因外界光线对玻璃培养皿折射光斑的干扰而影响统计精度的行业难题。
-------------------------------------------------------------------------
5、螺旋菌落分析功能,支持所有品牌的螺旋接种仪
“迅数”螺旋平皿分析系统最大的特定是它的包容性,不仅严格按照美国的FDA螺旋计数法则设计,
而且已经纳入中华人民共和国出入境检验检疫行业标准《食品和化妆品中的细菌计数检验法——螺旋平板法》,
可以适应所有品牌螺旋接种仪的接种模式要求。
-------------------------------------------------------------------------------------------------------------------------
6、强大的区域选择功能特别适合局部有片状生长和污染,而其他部分菌落
分布很均匀平皿可任意选择圆形、矩形、扇形、半圆和任意多边形等工具,
自动计算出该区域内的菌落数,或自动排除污染区域的菌落数。
通过平皿直径和稀释度数据,并自动换算为全皿菌落总数。


| 参数名称 | 参数值 |
|---|---|
| CCD | 300像素 |
| 分辨率 | 0.08mm |
| 图像拍摄 | 自动聚焦、自动白平衡、自动色温控制 |
| 动态监视 | 培养皿实时预览、区域放大导航、多培养皿图像队列 |
| 图像调节 | 灰度图、负相图转换、亮度、对比度、饱和度调节、RGB调节 |
| 可观测平皿直径 | 50mm—110mm |
| 拍摄箱 | 全封闭、无日光干扰、自动居中、暗箱拍摄 |
| 上光源 | 全空间、宽光带 |
| 下光源 | LED悬浮式暗视野 |
| 菌落识别技术 | ColonfastTM 菌落智能识别技术 |
| 统计速度 | 1秒>300个菌落 |
| 全皿自动统计 | 菌落总数统计,并按5档尺寸分类显示 |
| 区域选择统计 | 可选择半圆、矩形、扇形、多边形区域进行统计 |
| 鼠标点击统计 | 快捷、方便,尤其适合培养皿边缘菌落的计数 |
| 人工计数修正 | 可手动修正统计结果,进一步提高统计精度 |
| 排除污染区域计数 | 选择污染区域可整体排除 |
| 统计效果监视 | 监视菌落分析的精度 |
| 直径分类统计 | 设置直径范围,统计特定大小的菌落 |
| 颜色识别统计 | 根据色度、亮度、饱和度筛选特定菌落 |
| 菌落粘连分割 | 自动分割相互粘连的菌落,链状菌落由用户选择分割或不分割 |
| 自动杂质剔除 | 根据形态、尺寸、颜色等方面的区别,进行自动杂质剔 |
| 菌落形态分析 | 仅需2秒就自动测出所有菌落的面积,直径,周长,圆度 |
| 自动换算功能 | 培养皿直径、样本稀释度输入,实现自动换算 |
| 螺旋平皿统计 | 根据FDA标准自动计数螺旋平板 |
| 仪器标定 | 仪器自带标定、人工修正标定 |
| 精确测量 | 通过鼠标拖动进行精确测量直线、角度 |
| 数据安全 | 操作者使用权限,数据修改权限设置 |
| 数据库 | 统计数据/图像自动存储、智能查询、Excel表导出 |
| 报表功能 | 提供报告编写模板、文本输入、打印预览 |
| 仪器配置 | V3型全自动菌落计数仪主机(含V3型菌落软件1台、品牌计算机(主机、显示器、鼠标、键盘)1台 |
注:本站商品信息均来自于厂商,其真实性、准确性和合法性由信息拥有者(厂商)负责。本站不提供任何保证,并不承担任何法律责任。
注:本站商品信息均来自于厂商,其真实性、准确性和合法性由信息拥有者(厂商)负责。本站不提供任何保证,并不承担任何法律责任。
注:本站商品信息均来自于厂商,其真实性、准确性和合法性由信息拥有者(厂商)负责。本站不提供任何保证,并不承担任何法律责任。
京公网安备 11010802034257号

